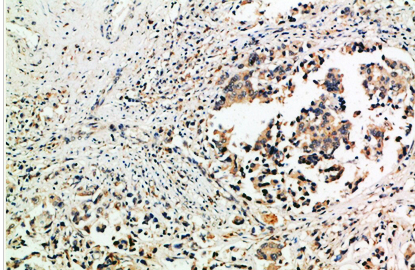

![]() All products will pass 3 times strict QC before delivery.
All products will pass 3 times strict QC before delivery.
![]() One-year shelf life.
One-year shelf life.
![]() Free 24T test ELISA kit.
Free 24T test ELISA kit.
![]() Powerful technical support
Powerful technical support
![]() Regular promotion.
Regular promotion.
![]() Guarantee of after-sales service.
Guarantee of after-sales service.
Filter by